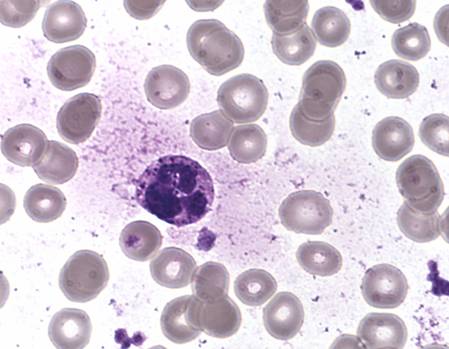

2010年12月18日
眼科急診
首先一個是年輕女性,因戴隱形眼鏡戴太久導致Corneal ulcer
這個病人戴了4天的放大鏡片,而且常常這樣做
據說隱形眼鏡戴5小時角膜就開始缺氧,難怪它的角膜破了好幾個大洞
眼科醫生建議,與其戴隱形眼鏡;倒不如做近視雷射手術
因為隱形眼鏡的副作用實在太多了,感染不說;角膜缺氧、破皮、水腫通通都是
再來一個是HTN Crisis的照會
之前課堂上有學過高血壓、糖尿病等等對視網膜的損害
不過一直到看過這位病人的眼底後,我才知道那是什麼樣的畫面
視網膜黃色的背景全部變成黃褐色的模樣,參雜著Choroid layer的血管
視野下只剩Optic disc是黃色的,C/D ratio至少也90%以上,學長說有Pale disc
另外還有Silvery white artery與Vein交錯:AV nicking
整個眼底看起來,非常地枯槁
實際看過一次,著實比課堂上得還印象深刻
2010年12月11日
2010年11月12日
系會費
會進到我們系的人,從小大概都是老師眼中的好學生
要當一個好學生不難,反正書讀好成績考好不鬧事
只要這樣,大概老師家長同學甚至遠房的親戚,都會覺得你就是好學生
無時無刻都拉著小孩要他們向你看齊
從幼稚園到大學,我們已經當了好久的學生
我相信能從聯考制度生存下來的我們各個深諳「好學生」之道
只是這樣的制度篩選出來的好學生,就會是一個好醫生嗎?
我認為醫師除了知識、技術、溝通能力之外
還一定得具有關懷它人的心、及最基本的公民素養
懂得爭取好成績的人,在其它項目的表現不一定好
甚至有時候,我們還單純為了爭取成績而非增進知識 (像是考古題)
深諳好學生之道的我們對於成績的重視遠大於其它項目
這樣子的教育培養出來的醫生真的適任嗎?
我看到許多人對於上課要點名簽到感到不滿
我看到許多人在老師分享人文關懷等書本以外的知識
就樂得埋頭經營自己的事,覺得課程空洞、沒有內容
我看到許多人願意投入數小時時間振筆疾書於內容空洞的考題;卻不願意花10分鐘好好回答一個教學問卷,改善我們的學習環境
更扯的,還有人會囑咐千萬不要反映上級的錯,以免分數被扣
我從這些事看到一個個被培養出來的「好學生」的影子,卻深深的不以為然
說回系會費,根據系學會的公告
大一迎新舞會、宿營的補助根本超過了大一學生所交的系會費總額
這些缺額是靠其它年級所交的系會費來補
其它包括FTP、各項節目活動、火鍋會、系隊補助等等都靠系費的繳交支撐
低年級的時候,我們享受較多的活動,可是沒有繳比較多的錢
因為高年級學長姐享受活動較少,由它們所交彌補低年級的開銷
可是高年級的時候,屬於我們的活動少了
我們覺得沒享受到系會提供的服務,於是就不繳錢了
哇靠這是對的嗎?
這不就像享受完健保方便後便回到旅居國外的華僑一樣
我們都知道幹醮那些健保掮客
卻不知道自己是不是也跟他們一模一樣
以我的觀點,這些時機點就是看人最好的時刻
發於心,形於外
我們做的每項決定,都反映出那些成績無法考核的項目
我曾經欣賞的許多同學,也因此而形象大打折扣
我們都知道該做對的事,可是常常我們一入淤泥就很難「不染」了
我自己知道自己也做得不好,很多上述的標準沒有達到
即使是五十步笑百步,但我也深深相信
至少我們要知道該怎麼明辨是非,認清正確之道
我相信,明辨是非這件事,遠比只懂得追求分數的心重要得太多太多
2010年10月10日
阿娟肉粽魯麵
這是一家只賣肉粽、魯麵、鹹粥的店,但往往12點不到便大排長龍
這家店有個特點就是:
外帶要排隊;但如果是內用的話直接點餐即可(千萬不要傻傻地排隊唷)
鹹粥星期一到五有不同口味
這次我禮拜六去沒有賣粥,只吃到它的魯麵
下圖是50元小碗的魯麵,可以看到整碗滿滿的都是料
尤其是它當場現做的肉羹,又多又好吃,配上酸酸甜甜的魯麵湯底真是過癮
魯麵是10:30開賣,在12點前可能就會賣完,賣完就沒了
像今天12點以後來的客人就只有肉粽可以吃,不過感覺它的粽子也很可口
阿娟肉粽魯麵
地址:台南市國華街三段87號
電話:06-2206812
價格:
魯麵鹹粥:小碗50、大碗65
肉粽:30/顆
2010年9月22日
中研院跟研究總心得
輾轉得到了機會,到中研院這個應該是台灣最好的研究環境,也著實增長了不少見聞

 初次到這,中研院給我的印象就像是間大學,只是沒有系、座落的建築物通通是研究所
初次到這,中研院給我的印象就像是間大學,只是沒有系、座落的建築物通通是研究所裡面也有便宜的員工餐廳、還有大型體育館、有折扣的便利商店
院區外面的商家也不少,主要以賣吃的為大宗
研究室方面,每個研究所裡面有多個中研院院士
每個院士有自己的研究室,經營自己的研究主題
國家依據該研究室的研究成果(ex: 發表論文數量)、研究計畫來審核撥給研究室的經費
院士(研究室主人)得到經費後,便可以請人(ex: 博士後研究員、研究助理、工讀生....等)來進行自己主題方面的研究
(所以如果對實驗室的研究主題沒有興趣的話,應徵者最好還是去找其它實驗室)
如果成果不理想,經費就會裁撤,研究室就得縮水或關門

比較讓我意外的是,來之前
我以為中研院是充滿著一群訓練有素的人在進行非常有效率研究的機構
但其實裡面也是有許多剛來、正在training中的學習者
所以如果想進中研院當研究助理、不用擔心,只要勇於應徵就會有機會
另外一群常常會在中研院出現的族群是:廠商業務
這些人之中有一部分可能是曾經在中研院當過助理或做過研究的人
除了推銷器材外、甚至有時還可以教研究助理如何做某些特殊的實驗
例如像我這次來跟研究,就是由廠商業務教我們如何做qPCR
實驗室裡面,通常給人感覺很凌亂的感覺
一來瓶瓶罐罐本來就很多;二來不管做任何實驗都免不了要準備一堆東西上桌;加上養的實驗動物、電腦座位等等。一整個很容易凌亂



果蠅養起來比小鼠還方便得多,空間小,犧牲後要處理也比較容易
整個暑假下來,我在中研院看過/學過的東西總共有:
練習寫實驗企劃書/成果報告書:


PCR、做膠、跑膠、切膠、用紫外光判讀

解剖顯微鏡的使用(我切的是老鼠14.5天胚胎!!)

qPCR的學習(這個定量的東西真的得萬分小心,因為它萬分地昂貴):另外還因此練習了Pipet的使用及Nanodrop分光光度計的練習

Western blot、壓片(只跟在學長旁邊看,做一次要2~3天,真的是很繁瑣的一件事)

雖然整個暑假我沒有做到很多事情,也沒有做出什麼實質的東西
但我還是覺得有點累,實驗室的這一塊可以對我說是全然未知的領域了
中研院的研究環境真的是不錯,組織學課本上提到的Western blot、FISH、ChIP、IHC、Flow cytometry都可以在這邊實際操作
能用這些新穎的器材從事有興趣的研究工作,這裡應該會是個不錯的夢工廠
2010年9月16日
一隻手對ICU病人的意義
昨天我的病人開完腦下垂體腫瘤後住到外科加護病房
晚上我去看她、寫progress note
病人剛開完刀,口鼻沾著血跡、眼睛半張、虛弱地躺在床上
「宋小姐,你現在有沒有什麼地方不舒服?」話剛說出口我就後悔了
病人已經虛弱成這樣,我還要人家來回答我問題?
只是她還是吃力地跟我說頭痛、想吐、嘴巴乾...等
我一邊安撫她一邊解釋為什麼會有這些副作用,希望自己感覺像個醫生
另一方面也因為這是我僅僅能做的少數事情之一
在這裡我什麼都不知道,什麼都不會做 (就是笨蛋一個)
連病人在我面前嘔吐,除了衛生紙,我不知道我還能給她什麼
我深深覺得自己沒有把醫療人員的角色扮演好,也沒有做好功課就來看病人
「還有什麼是我能幫你的嗎?」抄完我要的資料,原已打算逃離的我再次問了她
「...我...手...」 (我頭靠近她的耳朵再聽一次)
「....可不可...以...讓我拉...你的...手」
我馬上把手給她
病人緩緩伸出她的手,卻用力地握著...
我待了10多分鐘,即使那場景在忙碌擁擠的ICU不是很自然
我腦中思考著病人的要求、想著我的手能帶給她什麼
--
今天她的情況好轉,轉到普通病房
我去看她紀錄病情,她一見到我就跟我道謝,謝謝我昨天晚上的陪伴
問完必要的資料後,基於好奇
我詢問她身體虛弱時,在加護病房是什麼感受
加護病房住著的往往是病情較嚴重、或是快速變化中的病人
從她的回答我感覺到
即使旁邊有護士醫生頻繁地照顧、來往
但病人卻有種,好像自己跟旁人處在不同世界的感覺
耳朵外、眼睛外面的世界,一團吵雜;眼皮下的世界,是不清楚的神智及疼痛的感受
張開眼醒來,不知自己躺了多久、此時是幾分幾刻
自己的世界混沌扭轉,似乎遠到再也無法回到外面井然有序的世界
這時候一隻握得到的手,是一條堅固的聯繫
提醒自己,我還活著、並且依然與那個世界牽連著
靠著這個聯繫,我可以安心地知道自己沒有默默地死去、我仍存在這個世界上!
有個人在那兒拉我一把,我就能更早回去
當時一個小小的舉動,讓病人在今晚一再地感謝我
讓我印象非常深刻
也讓我知道,住在加護病房的患者
是多麼害怕自己就此再也回不來這個世界
而僅僅是一個握手的小動作,能在當時給病人多大的心理支撐
上星期的門診,有一個故事值得紀錄一下。
一位腦下垂體腫瘤的女病人,開完刀出院第一次回診,問診結束後,她很慎重的告訴我下面這一件事:⋯⋯
「洪醫師,很感謝你幫我做的手術很成功,有一個跟著你的實習醫師XXX(其實是見習醫師)我也要特別感謝他。開完刀當天,我醒來的時候發現自己在加護病房,身體非常的虛弱,連講話的力氣都沒有,周圍一些機器的聲音聽起來又讓人很害怕。不知道過了多久,XXX醫師出現在我面前,他想瞭解我的狀況,問了一些問題,但我身體很不舒服只能搖頭不想回答,但他沒有因此離開,反而想了一下很親切的問我:『那麼有什麼是我現在可以幫妳的?』…『我的手讓妳握著好不好?』我很感動的點點頭,於是我抓著他的手不知道多久昏昏沉沉的睡著了…」
2010年值得紀錄的一隻手(二)
「是他溫暖的手,幫助我度過在加護病房裡的那一個無助的夜晚…洪醫師,你一定要幫我轉告他我很感謝他!而且你一定要幫他加分!」
是的,我想起這件事了,隔天同學很高興的跑來跟我報告時,我還跟他開玩笑說「因為你是一個陌生的年輕男子啊,所以她很高興!」
⋯⋯
看來身為一個老師,我還有很多需要學習的地方。
原來,病人後來回診時還跟老師提起這件事,老師還特地記下此事
這真的是一個很好的reward
2010年9月11日
難忘的手術房經驗
穿梭於各間手術房之餘也看了不少之前沒看過的手術
前幾天看了一個印象最深的
病人進來時感覺就很虛弱,帶著NG進來,要做的是explore larpartomy,且懷疑有volvulus
一打開肚子就看到小腸脹得比正常的大腸還大,上面有的血絲怒張、有的已呈暗紅(快黑掉了)
外科探查一陣子後發現胃也脹得很厲害,叫麻醉醫師做NG suction
這才發現,病人的bowel content已經有部份從嘴巴,流出來了!!!
顏色就像腹瀉
這時候不只是NG suction的問題了,我想學姐應該更擔心Aspiration的問題
而且病人這時候血壓掉,Mean應該只有4X mmHg
外科R看了我一眼,說:
『學弟,快來幫忙』
於是接下來我就去Call VS、做Suction
V來了之後一群人慌亂了一陣,總算是搞定病人狀況
2010年8月28日
IE6真奇怪
發現自己的blog跟在IE6下跟Firefox及Chrome的外觀大不同
但是目前沒有打算為了IE6做什麼調整
待會再來看看IE8下的瀏覽效果
2010年8月26日
觀後感-蘇西的世界
這部電影描述一名14歲少女在被殺害後
她身邊的人(及兇手),在事件過後,各自如何度過自己生活的故事
看完這部電影,離去時心理帶著一股沉重和悲傷的情緒
那是種溫馨、感動、不平及一部分未知的感覺
這種感受,是看其它電影所沒有的
電影的一開始就告訴我們:蘇西-賽門,在她14歲時被她的鄰居殺害
大部分的劇情都是以蘇西靈魂在死後回顧她家人、朋友,及殺害她的兇手的過程中描述
這部電影的架構與以往其它電影有很大的不同
一開始,它就告訴我們主角死了
接著主角伴著我們,一邊串出謀殺案發生前後的種種事情
在另一邊,主角死後的靈魂也學著如何放下人世間她所掛念的種種:她的家人、朋友、喜歡的男生,還有殺害她的兇手
只有當蘇西能割捨這一切的時候,她的家人也才能走出傷痛;她的靈魂也才能渡往天堂
我覺得那部分我自己都搞不清楚的情緒,來自於這部電影特殊的敘述角度
電影中不時穿插著蘇西以第一人稱的角度描述劇情、描述兇手接下來的生活
每當蘇西在旁白中用天真不帶著憎恨(至少,我聽起來這樣覺得)說:「謀殺我的兇手是一個…,他…」時,立刻對比出兇手他所做的事,是有多麼地對不起蘇西
我想就是憐惜、不平蘇西及憎恨兇手的複雜情緒
就是這股五味雜陳無以名狀的情緒在電影結束後還一直迴繞在我心裡無法釋懷
好看
我想我是一個特別喜歡流淚電影的人
聽說小說版比短短2小時的電影更能原汁原味地描述完整的故事
(像:蘇西是被鄰居強暴分屍的、蘇西的媽媽後來跟賴恩警官外遇等等...)
不過這麼一來寫實面及人性的黑暗面就大大增加
我想電影版的應該是挑了較能普為大眾接受的部分拍攝吧
2010年8月21日
用deborphan清除Ubuntu中無用的函式庫
電腦會幫我們把相依的函式庫給一起裝起來
但是當我們用apt-get移除套件時,這些函式庫並不會一起被移除
久而久之這些"孤兒"函式庫就會累積在我們的系統中,佔據系統空間
要想清除這些無用的函式庫,我們可以用deborphan這個套件
首先到Synaptic或是在終端機下指令安裝deborphan
sudo apt-get install deborphan用deborphan查詢無用的函式庫,在終端機輸入:
deborphan -sPz(加入-s會顯示從哪一個套件來的;-P顯示套件重要性;-z顯示套件大小)
看起來會像這樣
youthyear@youthyear-laptop:~$ deborphan -sPz
172 main/libs gir1.0-pango-1.0 optional
120 main/libs gir1.0-atk-1.0 optional
260 main/libs libtelepathy-farsight0 optional這裡列出來的套件基本上已經是用不到的,可以用dpkg -P來移除它們
例如要移除上面的gir1.0-pango-1.0套件,在終端機輸入:
sudo dpkg -P gir1.0-pango-1.0這樣就可以清除掉電腦中的無用套件了
以上內容來自<<次世代 Linux – Ubuntu 玩全手冊>>
這是一本可以免費下載的Ubuntu入門書,推薦剛接觸Ubuntu的人一定要看看
2010年8月20日
安裝及使用Linux下的p7zip
要能支援更多解壓縮的格式,還是安裝p7zip(Linux下的7-zip)比較好
安裝:
到Synaptic套件管理程式安裝p7zip-full套件。它可以幫我們解常見的zip、rar、7z等格式
使用方法:
Linux下的p7zip並沒有圖形介面,所以安裝完後我們只能在終端機下指令來使用它
這會讓事情好像變得比較困難一些,我的作法是
把新拿到的壓縮檔下載到家目錄下(因為終端機一打開就位在此,方便操作)
接著要進行解壓縮,在終端機輸入:
7z x 檔案名稱.副檔名檔案就會解壓縮在家目錄下了,之後可以再移到想要的地方
如果想指定解壓縮到特地位置或是資料夾(這裡以解壓縮到桌面上的New資料夾為例)
可以在終端機輸入:
7z x 檔案名稱.副檔名 -o/home/使用者名稱/桌面/New(若是New不存在,系統會自行建立)
接下來,就交給程式跑囉(其實p7zip的效率很好唷)
2010年8月17日
Shutter-Linux系統下的桌面截圖軟體
在Windows底下有PicPick、Faststone Capture等軟體好用
Ubuntu下有沒有類似的軟體呢?
Shutter就是一個Linux系統下非常好的桌面截圖軟體
它提供的功能幫助你精準地截圖、並做簡單的標記、修飾
而且介面簡單易懂,非常好上手
程式名稱:Shutter
官方網站:http://shutter-project.org/
下載點:點此進入下載頁面
Shotwell圖片管理軟體-Ubuntu下的Picasa

Shotwell是一套Linux作業系統下的相片管理軟體 (Shotwell目前也有Windows版本了)
它的功能及介面有點像Windows下的Picasa
使用者將相片匯入程式後,它能幫助我們管理相片、做基本修圖及上傳到網路相簿(目前支援Facebook, Flicker, Picasa Web Albums)
程式名稱: Shotwell
官方網站: http://yorba.org/shotwell/
下載點: 點此進入下載頁面
Shotwell 0.6 支援的影像格式:以下是介面簡介
JPEG, PNG, RAW (目前尚不支援BMP, GIF, TIF)



小結:
雖然目前Shotwell功能及支援的影像格式尚且不及Windows下的Picasa豐富
但對我來說,它已經能滿足我對這類軟體的主要需求-簡易修圖、上傳相簿
著實是我在Ubuntu系統下的一個好幫手
2010年8月13日
在Ubuntu下安裝PDF XChange Viewer
它不但免費、啟動快速,還可以在pdf上畫螢光筆、標底線等作註記,是閱讀文章的好利器
Ubuntu裡一些pdf閱讀器其實效率很好,但如果說要有螢光筆畫記的功能
我還沒有找到一個非常滿意的程式
參考了Nelson的文章後,
透過Wine現在我在Ubuntu底下也可以用PDF XChange Viewer看pdf了
先安裝好Wine
到官方網站下載可攜版的PDF XChange Viewer軟體,(選Portable ZIP)
下載回來解壓縮後,將整個軟體資料夾(假定為A資料夾)移到
/home/你的帳號/.wine/dosdevices/c:/Program Files/底下
下載此執行腳本,用文件編輯器打開它,將第23行的位址指向Program Files底下A資料夾內的PDFXCview.exe檔 (在我的電腦是/home/youthyear/.wine/dosdevices/c:/Program Files/PDFX_Vwr_Port/PDFXCview.exe),好了後儲存
將這份檔案改成可執行檔。對它按右鍵>屬性>權限>勾選『允許檔案做為程式執行』
將它移動到「/usr/bin」底下 (若遇到權限不足的問題。可以下載這個檔案,把它改為可執行檔,之後執行它便可以用root開啟檔案總管)
Nelson大的文章上有提到接下來到終端機下sudo mv PDFXCview /usr/bin的指令,但是這邊我試過後會顯示抓不到這個檔案,不過這步驟一定要做,下面的步驟才會順利
選擇任一pdf檔,右鍵點選『以其它方式開啟』
接著選我們剛剛的PDFXCview,或是在『使用自訂的指令』那裡填上『/usr/bin/PDFXCview』
這時候再任選一pdf檔,右鍵>屬性>以此開啟> 選擇PDFXCview即可
2010年8月11日
Liu's stain下各種血球的特徵
觀念:
看大小不一定準:血球的大小為一範圍,單核球可以很小;淋巴球可以很大。需參考形態特徵辨別。
型態有多樣:不同病人、不同玻片染起來的顏色都不一樣,血球顆粒也沒有一定的大小。
光學顯微鏡下要驗明血球正身「沒有黃金準則」,只能判斷傾向何種血球;要確診惟靠其它進一步檢驗。
紅血球 (Erythrocyte, Red blood cell, RBC)
直徑: 7.5~8.3μm
細胞質: 雙凹(中央淡染),盤狀
細胞核: 無核

嗜中性球 (Neutrophil)
直徑: 10~15μm
細胞質: 含許多粉紅色的小顆粒。因顆粒小,轉動細調節輪只有清楚跟模糊之分
細胞核: 通常分2~5葉


嗜酸性球 (Eosinophil)
直徑: 10~15μm
細胞質: 充滿很有特色的橘紅色顆粒(有時候不一定很紅),有點像魚卵。比嗜中性球的顆粒還粗大,轉動細調節輪時可以感覺那些顆粒在閃爍
細胞核: 常見分2葉



嗜鹼性球 (Basophil)
直徑: 10~15μm
細胞質: 細胞膜邊緣不清楚。含粗大的紫黑色顆粒,有時顆粒會破掉不一定看得到
細胞核: 易被顆粒蓋住,有分葉但整體細胞核看不清楚

單核球 (Monocyte)
直徑: 15~20μm
細胞質: 含許多細小的紅色顆粒
細胞核: 型態多變,常見腎形或圓形。核染起來的顏色較不平均



- 單核球為最大的白血球(但切記也有體型小的單核球)。有時跟大淋巴球會容易搞混(大小相近),但淋巴球的細胞質較乾淨且稍偏藍色;單核球的細胞質感覺較髒、常見一些顆粒在其中
- 單核球的核可以有多種形狀呈現,且顏色染起來較不均勻;但淋巴球的核通常較圓,且顏色是均勻地深染
淋巴球 (Lymphocyte)
直徑: 大(12~15μm);中(10~12μm);小(8~10μm)
細胞質: 細胞質所佔比例很少,質內乾淨、色偏藍,一般無顆粒存在
細胞核: 為圓形或卵圓形,核深染且顏色較均勻



血小板 (Platelet, thrombocyte)

附表1.
各類血球正常情況下的百分比和數目參考值 (依數量多寡排列)
細胞類別 | 百分比 | 絕對數目 (單位:109個/L) |
Neutrophil | 40~75 | 2.75~7.5 |
Lymphocyte | 20~45 | 1.5~4.0 |
Monocyte | 2~10 | 0.2~0.8 |
Eosinophil | 1~6 | 0.04~0.4 |
Basophil | <1 | 0.01~0.1 |
相關資料:
關於血液抹片染色的歷史,以及各種染色(Wright's stain, Giemsa stain, Liu's stain, PAS stain)的簡介、做法。我有整理了一份PDF,需要的可供參考。
Reference
1. 數據資料: 郭啟昭, 周真玲編著, 1987, 彩色血液學圖譜, 合記圖書出版社
2. 血球特徵: 國泰醫院醫檢師
3. 圖片來源: 中研院沈哲鯤實驗室所拍
2010年8月10日
手
我的手似乎穩定性還不錯,可以拿來作一些手工藝
剛來實驗室的前幾個禮拜
跑膠要Load well,我的手抖得不會太厲害,最後DNA有集中到Well中
就手的穩定性這邊,有被稱讚一下
外科見習時我們用Larparoscope練習割紙上數字的照片
以下依序是Migo, R, 我, Wuz

雖然,這是花了滿多時間且耐心地慢慢剪的結果
或許可以走外科系?
2010年8月2日
感冒了,H1N1新流感?
病程&症狀:
前天晚上要睡覺前開始感覺喉嚨裡有痰,量不多咳不太出來,除此之外沒什麼不適
昨天早上起來,除了喉嚨的一點點痰以外還是沒什麼不適
午餐去吃雞肉飯,開始有食欲不振症狀
接著走回來宿舍的路上開始有嚴重地全身倦怠感、併發肌肉痠痛(上臂&小腿為主)
累到原本要用電腦的我不得不去躺一下
休息一下有好一些
接著打開電腦看Ubuntu的電子書,感覺無法專心沒多久又跑去玩續英傑傳
這之中除了倦怠感及肌肉痠痛外
開始有發燒(微燒,四肢末端會感覺熱熱的)、
頭痛(從眼眶、太陽穴一直延展到腦袋裡的悶痛)、
流鼻涕(稀疏的白色分泌物、量不大)
於是下午4點又跑去躺到6點
無力地出門去買晚餐
今天去實驗室才知道另外一個坐我旁邊的暑期研究生請假
因為他流感快篩陽性,目前在服用克流感
總結
兩天前開始喉嚨有痰
昨天中午到下午病程急遽變化:
食欲不振、發燒、頭痛、全身倦怠感及肌肉痠痛、鼻涕通通來
一直持續到今天
所幸的是沒有呼吸急促、高燒、心跳加速等症狀
但是「非常的不舒服」,感覺比之前的感冒還特別難過 (頭痛及全身倦怠感吧)
靜靜修養中
2010年7月30日
用Excel算Student’s t test
紀錄
假定A, B是同一物種的兩個群,我們針對I, II, III三種項目分別對A, B進行檢測,結果如下

我們想要比較A, B兩群體分別在I, II, III項目的表現上是否有統計上的差異
這時候這樣設定:
在想要填入P-value的空格處點一下

點選公式>插入函數

選擇TTest

分別框選A, B中想要比較的項目

Tail: 單尾分布填1, 雙尾分布填2
Type: 成偶填1, 具有相同變異數填2, 具有不同變異數填3

接著P-value就會自動幫你算好了
2010年7月25日
Real Time-PCR / Quantitative PCR Primer設計
使用軟體: ABI Primer Express 2.0
1.上NCBI,用Nucleotide資料庫找出所要的Gene sequence。把ATCG序列存下來到記事本(建議用Fasta偶模式存)
2.打開Primer Express,點選File>New>TagMan MGB Probe & Primer Design
3.點選Import DNA profile,選剛剛存下來含ATCG序列的記事本,程式會自動編排好
4.點選Options>Find Primers/Probes Now。程式會自動幫你找出可以當Primer/Probe的位置 (接下來我們人工要做的就是確定這段序列會不會有太多的CG鍵結,因為CG鍵結含3個氫鍵要打斷不像AT鍵結那麼容易

5.分頁切換到Primer

6.點選Options>Show Primer Secondary Structure。視窗會顯示出該段Primer的CG鍵結數目,依序比對直至找到適當序列

7.若沒有找到適當的Primer,把原來程式挑出來的位置給剔除,讓程式再找一次 (要是還找不到就真的沒辦法了)










